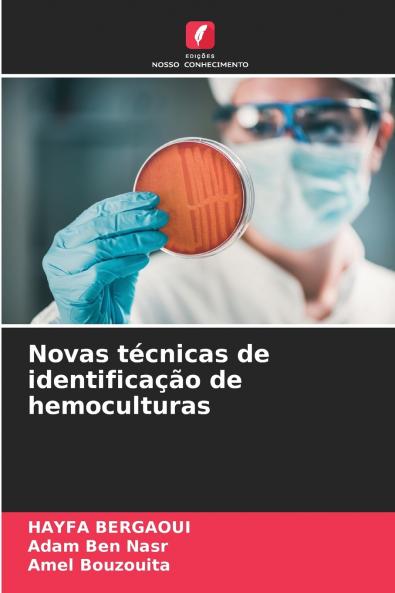
Novas técnicas de identificação de hemoculturas

Portuguese
Paperback
₹6712
₹8683
22.7% OFF
(All inclusive*)
Delivery Options
Please enter pincode to check delivery time.
*COD & Shipping Charges may apply on certain items.
Review final details at checkout.
Looking to place a bulk order? SUBMIT DETAILS
About The Book
Description
Author(s)
A bacteriémia é a principal causa de morte nas unidades de cuidados intensivos. O desenvolvimento de métodos rápidos permitiu reduzir a mortalidade devida a atrasos na terapêutica antibiótica adequada. As principais técnicas utilizadas são a ionização por dessorção de laser assistida por matriz a reação em cadeia da polimerase e a hibridação in situ por fluorescência. A cromatografia líquida acoplada à espetrometria de massa em tandem a cromatografia gasosa acoplada a um espetrómetro de mobilidade iónica e o ImmulexTM são técnicas de identificação utilizadas com menos frequência. Imagens de vídeo em tempo real FASTinov® sistema Uro4 HB&LTM sonda fluorogénica sistema de teste direto e rápido de suscetibilidade antimicrobiana recolha integrada de luz dispersa. O conhecimento do desempenho dos métodos utilizados é essencial para o seu controlo e fiabilidade. A implementação destas técnicas no laboratório deve ser cuidadosamente adaptada de acordo com uma série de factores incluindo o hospital as capacidades do laboratório os médicos e a população de doentes.
Delivery Options
Please enter pincode to check delivery time.
*COD & Shipping Charges may apply on certain items.
Review final details at checkout.
Details
ISBN 13
9786208229887
Publication Date
-25-10-2024
Pages
-72
Weight
-111 grams
Dimensions
-152x229x4.38 mm